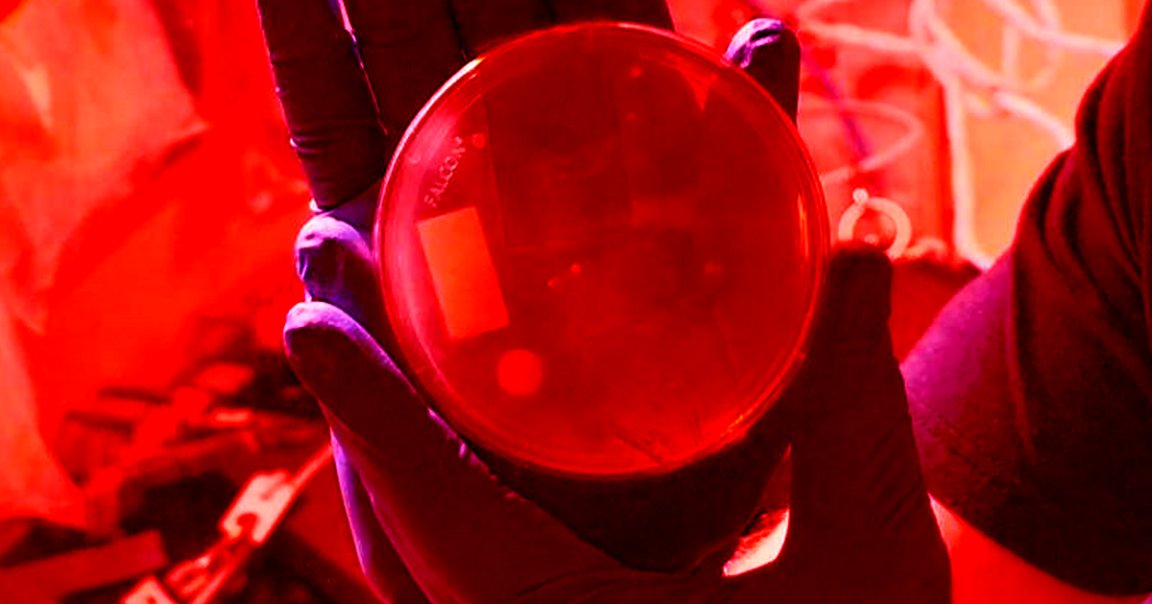

First Edit
Astronauts aboard the International Space Station just made CRISPR history.
On Thursday, astronauts Christina Koch and Nick Hague used the gene-editing technology to modify the yeast genome in a way that mimics radiation-caused damage to DNA. The experiment marked the first use of CRISPR in space — and it could help preserve the health of future astronauts.
Genes in Space
Koch and Hague may have carried out the first-of-its-kind experiment, but a team of Minnesota high school students designed it.
Those students were the 2018 winners of Genes in Space, a national science competition that ask students in grades 7 through 12 to submit ideas for DNA experiments to be carried out aboard the ISS.
Prior Preparation
The use of CRISPR to tinker with the yeast’s genome was just the first part of the experiment. In fact, the researchers were mostly interested in what happened next — they wanted to see how the organism would respond to the breaks they made, making note of the molecular changes that took place and any errors in the repair process.
The hope is that any insights gleaned from the experiment will help us better understand how human DNA might respond to the damage caused by increased radiation exposure in space — and possibly help us find ways to protect astronauts from that damage during longterm missions to Mars and beyond.
READ MORE: History in the Making: Student Experiment Edits DNA with CRISPR Technology in Space [ISS National Lab Blog]
More on space radiation: Here’s How Future Astronauts Could Survive the Radiation of Space